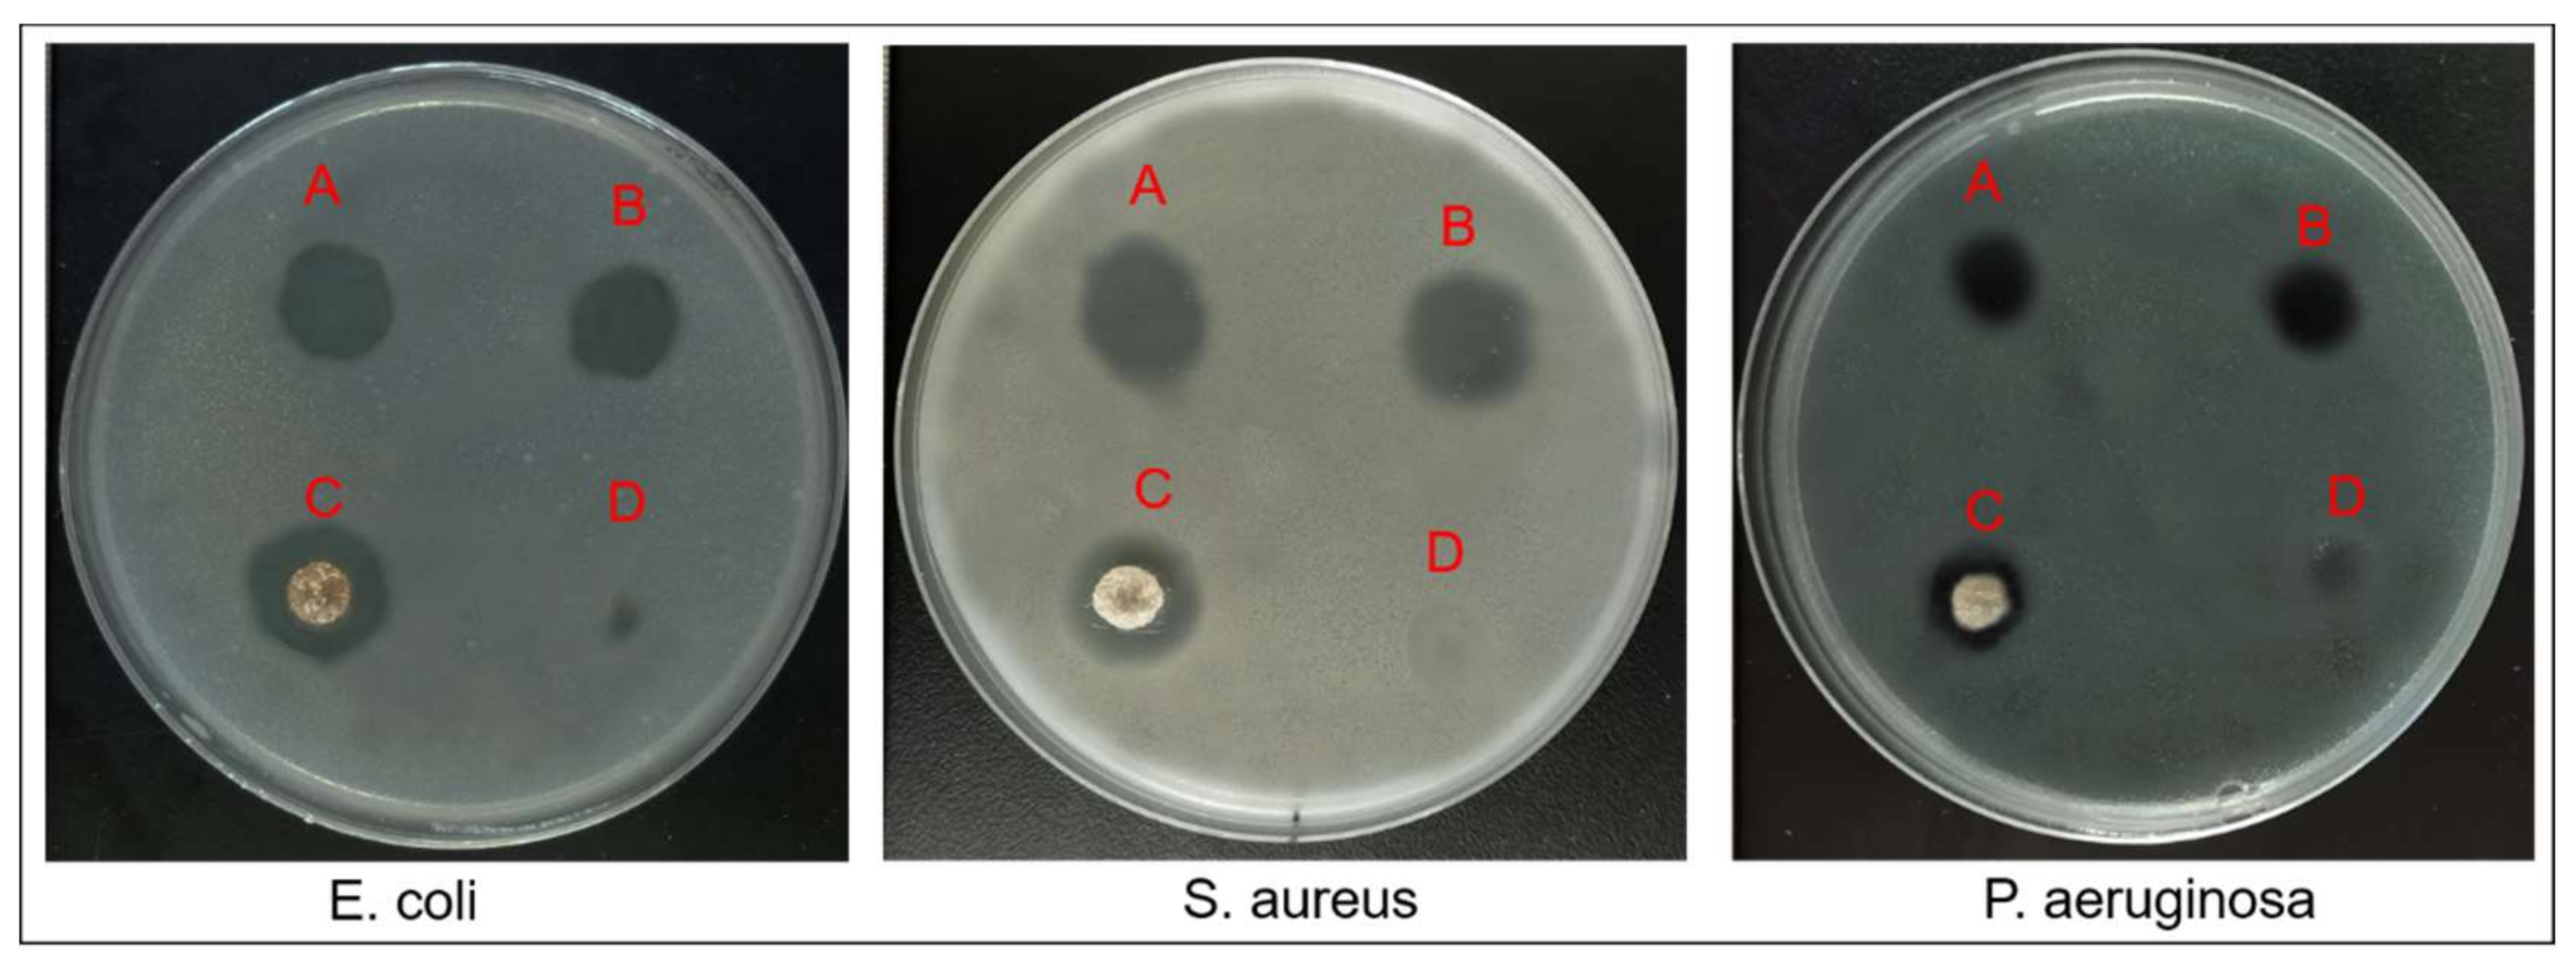
Nanomaterials 11 01546 g011 Nanomaterials 11 01546 g011

Multi-Functional Core-Shell Nanofibers for Wound Healing
Abstract
1. Introduction
2. Materials and Methods
2.1. Materials
2.2. Fabrication of Nanofibers via Centrifugal Spinning
2.2.1. Fabrication of Nanofibers without Drugs via Co-Axial Centrifugal Spinning
2.2.2. Fabrication of Monoaxial and Core-Shell Nanofibers with Drugs
2.3. Characterization of Nanofibers
2.3.1. Morphology and Structures
2.3.2. Viscosity
2.3.3. Contact Angle
2.3.4. Thermal Properties
2.3.5. Mechanical Tests
2.3.6. Characterization of Chemistry
2.4. In Vitro Drug Release Studies
2.5. Cell Viability Assay
2.6. Antibacterial Evaluation
2.7. Statistical Analysis
3. Results and Discussion
3.1. Design of Co-Axial Centrifugal Spinning Device for Producing Core-Shell Nanofiber
3.2. Characterizations of Nanofibers
3.2.1. Investigation of Parameter Control for Producing Core-Shell Nanofibers
3.2.2. Thermal Properties
3.2.3. Mechanical Properties
3.2.4. Fourier Transform Infrared Spectroscopy (FTIR)
3.2.5. Contact Angle Studies
3.3. In Vitro Drug Release Profile
3.4. Cell Viability Assessment
3.5. In Vitro Antibacterial Assessment
4. Conclusions
Supplementary Materials
Author Contributions
Funding
Institutional Review Board Statement
Informed Consent Statement
Data Availability Statement
Acknowledgments
Conflicts of Interest
References
- Cheng, G.; Yin, C.; Tu, H.; Jiang, S.; Wang, Q.; Zhou, X.; Xing, X.; Xie, C.; Shi, X.; Du, Y.; et al. Controlled Co-delivery of Growth Factors through Layer-by-Layer Assembly of Core–Shell Nanofibers for Improving Bone Regeneration. ACS Nano 2019, 13, 6372–6382. [Google Scholar] [CrossRef] [PubMed]
- Zhang, X.; Wang, C.; Liao, M.; Dai, L.; Tang, Y.; Zhang, H.; Coates, P.; Sefat, F.; Zheng, L.; Song, J.; et al. Aligned electrospun cellulose scaffolds coated with rhBMP-2 for both in vitro and in vivo bone tissue engineering. Carbohydr. Polym. 2019, 213, 27–38. [Google Scholar] [CrossRef] [PubMed]
- Rasool, A.; Ata, S.; Islam, A. Stimuli responsive biopolymer (chitosan) based blend hydrogels for wound healing application. Carbohydr. Polym. 2019, 203, 423–429. [Google Scholar] [CrossRef] [PubMed]
- Ali, I.H.; Khalil, I.A.; El-Sherbiny, I.M. Single-Dose Electrospun Nanoparticles-in-Nanofibers Wound Dressings with Enhanced Epithelialization, Collagen Deposition, and Granulation Properties. ACS Appl. Mater. Interfaces 2016, 8, 14453–14469. [Google Scholar] [CrossRef]
- Yu, D.-G.; Li, X.-Y.; Wang, X.; Yang, J.-H.; Bligh, S.W.A.; Williams, G.R. Nanofibers Fabricated Using Triaxial Electrospinning as Zero Order Drug Delivery Systems. ACS Appl. Mater. Interfaces 2015, 7, 18891–18897. [Google Scholar] [CrossRef]
- Cheng, J.; Jun, Y.; Qin, J.; Lee, S.-H. Electrospinning versus microfluidic spinning of functional fibers for biomedical applications. Biomaterials 2017, 114, 121–143. [Google Scholar] [CrossRef]
- Boda, S.K.; Chen, S.; Chu, K.; Kim, H.J.; Xie, J. Electrospraying Electrospun Nanofiber Segments into Injectable Microspheres for Potential Cell Delivery. ACS Appl. Mater. Interfaces 2018, 10, 25069–25079. [Google Scholar] [CrossRef]
- Brown, J.H.; Das, P.; DiVito, M.D.; Ivancic, D.; Tan, L.P.; Wertheim, J.A. Nanofibrous PLGA electrospun scaffolds modified with type I collagen influence hepatocyte function and support viability in vitro. Acta Biomater. 2018, 73, 217–227. [Google Scholar] [CrossRef]
- Rezk, A.I.; Unnithan, A.R.; Park, C.H.; Kim, C.S. Rational design of bone extracellular matrix mimicking tri-layered composite nanofibers for bone tissue regeneration. Chem. Eng. J. 2018, 350, 812–823. [Google Scholar] [CrossRef]
- Zhang, S.; Wang, X.-J.; Li, W.-S.; Xu, X.-L.; Hu, J.-B.; Kang, X.-Q.; Qi, J.; Ying, X.-Y.; You, J.; Du, Y.-Z. Polycaprolactone/polysialic acid hybrid, multifunctional nanofiber scaffolds for treatment of spinal cord injury. Acta Biomater. 2018, 77, 15–27. [Google Scholar] [CrossRef]
- Szentivanyi, A.; Chakradeo, T.; Zernetsch, H.; Glasmacher, B. Electrospun cellular microenvironments: Understanding controlled release and scaffold structure. Adv. Drug Deliv. Rev. 2011, 63, 209–220. [Google Scholar] [CrossRef]
- He, M.; Jiang, H.Y.; Wang, R.; Xie, Y.; Zhao, C.S. Fabrication of metrpnidazole loaded poly (epsilon-caprolactone)/zein core/shell nanofiber membranes via coaxial electrospinning for guided tissue regeneration. J. Colloid Interface Sci. 2017, 490, 270–278. [Google Scholar] [CrossRef]
- Yang, Y.; Xia, T.; Zhi, W.; Wei, L.; Weng, J.; Zhang, C.; Li, X. Promotion of skin regeneration in diabetic rats by electrospun core-sheath fibers loaded with basic fibroblast growth factor. Biomaterials 2011, 32, 4243–4254. [Google Scholar] [CrossRef]
- Khalf, A.; Madihally, S.V. Recent advances in multiaxial electrospinning for drug delivery. Eur. J. Pharm. Biopharm. 2017, 112, 1–17. [Google Scholar] [CrossRef]
- Weitz, R.T.; Harnau, L.; Rauschenbach, S.; Burghard, M.; Kern, K. Polymer Nanofibers via Nozzle-Free Centrifugal Spinning. Nano Lett. 2008, 8, 1187–1191. [Google Scholar] [CrossRef]
- Badrossamay, M.R.; Balachandran, K.; Capulli, A.K.; Golecki, H.M.; Agarwal, A.; Goss, J.A.; Kim, H.; Shin, K.; Parker, K.K. Engineering hybrid polymer-protein super-aligned nanofibers via rotary jet spinning. Biomaterials 2014, 35, 3188–3197. [Google Scholar] [CrossRef]
- Ren, L.; Pandit, V.; Elkin, J.; Denman, T.; Cooper, J.A.; Kotha, S.P. Large-scale and highly efficient synthesis of micro- and nano-fibers with controlled fiber morphology by centrifugal jet spinning for tissue regeneration. Nanoscale 2013, 5, 2337–2345. [Google Scholar] [CrossRef]
- Zhang, X.; Lu, Y. Centrifugal Spinning: An Alternative Approach to Fabricate Nanofibers at High Speed and Low Cost. Polym. Rev. 2014, 54, 677–701. [Google Scholar] [CrossRef]
- Badrossamay, M.R.; McIlwee, H.A.; Goss, J.A.; Parker, K.K. Nanofiber Assembly by Rotary Jet-Spinning. Nano Lett. 2010, 10, 2257–2261. [Google Scholar] [CrossRef]
- Dong, Y.; Mei, S.; Kong, L. Study on Fabrication Technology of Nanofiber through Centrifugal Rotor. Adv. Text. Technol. 2017, 25, 81–86. [Google Scholar]
- Vocetkova, K.; Buzgo, M.; Sovkova, V.; Rampichova, M.; Staffa, A.; Filova, E.; Lukasova, V.; Doupnik, M.; Fiori, F.; Amler, E. A comparison of high throughput core-shell 2D electrospinning and 3D centrifugal spinning techniques to produce platelet lyophilis-ate-loaded fibrous scaffolds and their effects on skin cells. RSC Adv. 2017, 7, 53706–53719. [Google Scholar] [CrossRef]
- Buzgo, M.; Rampichova, M.; Vocetkova, K.; Sovkova, V.; Lukášová, V.; Doupnik, M.; Mickova, A.; Rustichelli, F.; Amler, E. Emulsion centrifugal spinning for production of 3D drug releasing nanofibres with core/shell structure. RSC Adv. 2017, 7, 1215–1228. [Google Scholar] [CrossRef]
- Hassiba, A.J.; El Zowalaty, M.E.; Nasrallah, G.; Webster, T.J.; Luyt, A.S.; Abdullah, A.M.; Elzatahry, A.A. Review of recent research on biomedical applications of electrospun polymer nanofibers for improved wound healing. Nanomedicine 2016, 11, 715–737. [Google Scholar] [CrossRef] [PubMed]
- Xie, Z.W.; Paras, C.B.; Weng, H.; Punnakitikashem, P.; Su, L.C.; Vu, K.; Tang, L.P.; Yang, J.; Nguyen, K.T. Dual growth factor re-leasing multi-functional nanofibers for wound healing. Acta Biomater. 2013, 9, 9351–9359. [Google Scholar] [CrossRef] [PubMed]
- Yergoz, F.; Hastar, N.; Cimenci, C.E.; Ozkan, A.; Tekinay, T.; Guler, M.O.; Tekinay, A.B. Heparin mimetic peptide nanofiber gel promotes regeneration of full thickness burn injury. Biomaterials 2017, 134, 117–127. [Google Scholar] [CrossRef] [PubMed]
- Pereira, R.F.; Bartolo, P.J. Traditional Therapies for Skin Wound Healing. Adv. Wound Care 2016, 5, 208–229. [Google Scholar] [CrossRef] [PubMed]
- Jayakumar, R.; Prabaharan, M.; Kumar, P.S.; Nair, S.; Tamura, H. Biomaterials based on chitin and chitosan in wound dressing applications. Biotechnol. Adv. 2011, 29, 322–337. [Google Scholar] [CrossRef] [PubMed]
- Pakravan, M.; Heuzey, M.-C.; Ajji, A. A fundamental study of chitosan/PEO electrospinning. Polymer 2011, 52, 4813–4824. [Google Scholar] [CrossRef]
- Kong, B.; Mi, S. Electrospun Scaffolds for Corneal Tissue Engineering: A Review. Materials 2016, 9, 614. [Google Scholar] [CrossRef]
- Lemma, S.M.; Bossard, F.; Rinaudo, M. Preparation of Pure and Stable Chitosan Nanofibers by Electrospinning in the Presence of Poly(ethylene oxide). Int. J. Mol. Sci. 2016, 17, 1790. [Google Scholar] [CrossRef]
- Li, H.; Cheng, F.; Gao, S.; Wu, Z.; Dong, L.; Lin, S.; Luo, Z.; Li, X. Preparation, characterization, antibacterial properties, and hemostatic evaluation of ibuprofen-loaded chitosan/gelatin composite films. J. Appl. Polym. Sci. 2017, 134. [Google Scholar] [CrossRef]
- Zhu, C.; Lei, H.; Fan, D.; Duan, Z.; Li, X.; Li, Y.; Cao, J.; Wang, S.; Yu, Y. Novel enzymatic crosslinked hydrogels that mimic extracellular matrix for skin wound healing. J. Mater. Sci. 2018, 53, 5909–5928. [Google Scholar] [CrossRef]
- da Silva, S.B.; Krolicka, M.; van den Broek, L.A.M.; Frissen, A.E.; Boeriu, C.G. Water-soluble chitosan derivatives and pH-responsive hydrogels by selective C-6 oxidation mediated by TEMPO-laccase redox system. Carbohydr. Polym. 2018, 186, 299–309. [Google Scholar] [CrossRef]
- Chen, W.; Zhi, M.; Feng, Z.; Gao, P.; Yuan, Y.; Zhang, C.; Wang, Y.; Dong, A. Sustained co-delivery of ibuprofen and basic fibroblast growth factor by thermosensitive nanoparticle hydrogel as early local treatment of peri-implantitis. Int. J. Nanomed. 2019, 14, 1347–1358. [Google Scholar] [CrossRef]
- Ridolfi, D.M.; Lemes, A.P.; De Oliveira, S.; Justo, G.Z.; Palladino, M.V.; Durán, N. Electrospun poly(ethylene oxide)/chitosan nanofibers with cellulose nanocrystals as support for cell culture of 3T3 fibroblasts. Cellulose 2017, 24, 3353–3365. [Google Scholar] [CrossRef]
- Shariful, M.I.; Sharif, S.B.; Lee, J.J.L.; Habiba, U.; Ang, B.C.; Amalina, M.A. Adsorption of divalent heavy metal ion by meso-porous-high surface area chitosan/poly (ethylene oxide) nanofibrous membrane. Carbohydr. Polym. 2017, 157, 57–64. [Google Scholar] [CrossRef]
- Spasova, M.; Spasova, O.; Manolova, N.; Rashkov, I.; Altankov, G. Preparation of PLIA/PEG nanofibers by electrospinning and potential applications. J. Bioact. Compat. Polym. 2007, 22, 62–76. [Google Scholar] [CrossRef]
- Groeber, F.; Holeiter, M.; Hampel, M.; Hinderer, S.; Schenke-Layland, K. Skin tissue engineering—In vivo and in vitro applications. Adv. Drug Deliv. Rev. 2011, 63, 352–366. [Google Scholar] [CrossRef]
- Ulubayram, K.; Cakar, A.N.; Korkusuz, P.; Ertan, C.; Hasirci, N. EGF containing gelatin-based wound dressings. Biomaterials 2001, 22, 1345–1356. [Google Scholar] [CrossRef]
- Choi, J.S.; Leong, K.W.; Yoo, H.S. In vivo wound healing of diabetic ulcers using electrospun nanofibers immobilized with human epidermal growth factor (EGF). Biomaterials 2008, 29, 587–596. [Google Scholar] [CrossRef]
- Li, Z.; Mei, S.; Dong, Y.; She, F.; Kong, L. High Efficiency Fabrication of Chitosan Composite Nanofibers with Uniform Morphology via Centrifugal Spinning. Polymers 2019, 11, 1550. [Google Scholar] [CrossRef] [PubMed]
- Erickson, A.E.; Edmondson, D.; Chang, F.-C.; Wood, D.; Gong, A.; Levengood, S.L.; Zhang, M. High-throughput and high-yield fabrication of uniaxially-aligned chitosan-based nanofibers by centrifugal electrospinning. Carbohydr. Polym. 2015, 134, 467–474. [Google Scholar] [CrossRef] [PubMed]
- Lu, Y.; Li, Y.; Zhang, S.; Xu, G.; Fu, K.; Lee, H.; Zhang, X. Parameter study and characterization for polyacrylonitrile nanofibers fabricated via centrifugal spinning process. Eur. Polym. J. 2013, 49, 3834–3845. [Google Scholar] [CrossRef]
- Ren, L.; Ozisik, R.; Kotha, S.P.; Underhill, P.T. Highly Efficient Fabrication of Polymer Nanofiber Assembly by Centrifugal Jet Spinning: Process and Characterization. Macromolecules 2015, 48, 2593–2602. [Google Scholar] [CrossRef]
- Padron, S.; Fuentes, A.; Caruntu, D.; Lozano, K. Experimental study of nanofiber production through forcespinning. J. Appl. Phys. 2013, 113, 024318. [Google Scholar] [CrossRef]
- Chang, W.-M.; Wang, C.-C.; Chen, C.-Y. The combination of electrospinning and forcespinning: Effects on a viscoelastic jet and a single nanofiber. Chem. Eng. J. 2014, 244, 540–551. [Google Scholar] [CrossRef]
- Al-Kattan, A.; Nirwan, V.P.; Munnier, E.; Chourpa, I.; Fahmi, A.; Kabashin, A.V. Toward multifunctional hybrid platforms for tissue engineering based on chitosan(PEO) nanofibers functionalized by bare laser-synthesized Au and Si nanoparticles. RSC Adv. 2017, 7, 31759–31766. [Google Scholar] [CrossRef]
- Hwang, T.; Kim, J.; Joshi, M.K.; Park, C.H.; Kim, C.S. Simultaneous regeneration of calcium lactate and cellulose into PCL nanofiber for biomedical application. Carbohydr. Polym. 2019, 212, 21–29. [Google Scholar] [CrossRef]
- Chen, C.W.; Don, T.-M.; Yen, H.-F. Enzymatic extruded starch as a carbon source for the production of poly(3-hydroxybutyrate-co-3-hydroxyvalerate) by Haloferax mediterranei. Process. Biochem. 2006, 41, 2289–2296. [Google Scholar] [CrossRef]
- Kelley, A.S.; Mantzaris, N.V.; Daoutidis, P.; Srienc, F. Controlled Synthesis of Polyhydroxyalkanoic (PHA) Nanostructures inR. eutropha. Nano Lett. 2001, 1, 481–485. [Google Scholar] [CrossRef]
- Rumschöttel, J.; Kosmella, S.; Prietzel, C.; Appelhans, D.; Koetz, J. Change in size, morphology and stability of DNA polyplexes with hyperbranched poly(ethyleneimines) containing bulky maltose units. Colloids Surf. B Biointerfaces 2016, 138, 78–85. [Google Scholar] [CrossRef]
- An, Q.; Xu, W.; Hao, L.; Huang, L. Cationic fluorinated polyacrylate core-shell latex with pendant long chain alkyl: Synthesis, film morphology, and its performance on cotton substrates. J. Appl. Polym. Sci. 2012, 127, 1519–1526. [Google Scholar] [CrossRef]
- Xu, W.; An, Q.; Hao, L.; Huang, L. Synthesis, film morphology, and performance of cationic fluorinated polyacrylate emulsion with core-shell structure. J. Appl. Polym. Sci. 2012, 125, 2376–2383. [Google Scholar] [CrossRef]
- Mumtaz, T.; Abd-Aziz, S.; Rahman, N.A.; Yee, P.L.; Wasoh, H.; Shirai, Y.; Hassan, M.A. Visualization of Core-Shell PHBV Granules of Wild Type Comamonas sp EB172 In Vivo under Transmission Electron Microscope. Int. J. Polym. Anal. Charact. 2011, 16, 228–238. [Google Scholar] [CrossRef]
- Hoare, T.; Pelton, R. Calorimetric Analysis of Thermal Phase Transitions in Functionalized Microgels. J. Phys. Chem. B 2007, 111, 1334–1342. [Google Scholar] [CrossRef]
- Yaseen, H.; Baltianski, S.; Tsur, Y. Effect of Incorporating Method of Niobium on the Properties of Doped Barium Titanate Ceramics. J. Am. Ceram. Soc. 2006, 89, 1584–1589. [Google Scholar] [CrossRef]
- Singh, R.; Ahmed, F.; Polley, P.; Giri, J. Fabrication and Characterization of Core–Shell Nanofibers Using a Next-Generation Airbrush for Biomedical Applications. ACS Appl. Mater. Interfaces 2018, 10, 41924–41934. [Google Scholar] [CrossRef]
- Cheng, J.; Li, H.; Cao, Z.; Wu, D.; Liu, C.; Pu, H. Nanolayer coextrusion: An efficient and environmentally friendly mi-cro/nanofiber fabrication technique. Mater. Sci. Eng. C 2019, 95, 292–301. [Google Scholar] [CrossRef]
- Zhu, X.; Cui, W.; Li, X.; Jin, Y. Electrospun Fibrous Mats with High Porosity as Potential Scaffolds for Skin Tissue Engineering. Biomacromolecules 2008, 9, 1795–1801. [Google Scholar] [CrossRef]
- Alharbi, H.F.; Luqman, M.; Khalil, K.A.; Elnakady, Y.A.; Elkader, O.A.; Rady, A.M.; Alharthi, N.H.; Karim, M.R. Fabrication of core-shell structured nanofibers of poly (lactic acid) and poly (vinyl alcohol) by coaxial electrospinning for tissue engineering. Eur. Polym. J. 2018, 98, 483–491. [Google Scholar] [CrossRef]
- Aydogdu, A.; Sumnu, G.; Sahin, S. A novel electrospun hydroxypropyl methylcellulose/polyethylene oxide blend nanofibers: Morphology and physicochemical properties. Carbohydr. Polym. 2018, 181, 234–246. [Google Scholar] [CrossRef] [PubMed]
- Han, W.; Xie, S.; Sun, X.; Wang, X.; Yan, Z. Optimization of airflow field via solution blowing for chitosan/PEO nanofiber formation. Fibers Polym. 2017, 18, 1554–1560. [Google Scholar] [CrossRef]
- Antunes, B.; Moreira, A.; Gaspar, V.; Correia, I. Chitosan/arginine–chitosan polymer blends for assembly of nanofibrous membranes for wound regeneration. Carbohydr. Polym. 2015, 130, 104–112. [Google Scholar] [CrossRef] [PubMed]
- Lin, L.; Dai, Y.; Cui, H. Antibacterial poly(ethylene oxide) electrospun nanofibers containing cinnamon essential oil/beta-cyclodextrin proteoliposomes. Carbohydr. Polym. 2017, 178, 131–140. [Google Scholar] [CrossRef]
- Marano, S.; Barker, S.A.; Raimi-Abraham, B.T.; Missaghi, S.; Rajabi-Siahboomi, A.; Craig, D.Q. Development of micro-fibrous solid dispersions of poorly water-soluble drugs in sucrose using temperature-controlled centrifugal spinning. Eur. J. Pharm. Biopharm. 2016, 103, 84–94. [Google Scholar] [CrossRef]
- Aliabadi, M.; Irani, M.; Ismaeili, J.; Piri, H.; Parnian, M.J. Electrospun nanofiber membrane of PEO/Chitosan for the adsorption of nickel, cadmium, lead and copper ions from aqueous solution. Chem. Eng. J. 2013, 220, 237–243. [Google Scholar] [CrossRef]
- Ko, J.E.; Ko, Y.-G.; Kim, W.I.; Kwon, O.K.; Kwon, O.H. Nanofiber mats composed of a chitosan-poly(d,l-lactic-co-glycolic ac-id)-poly(ethylene oxide) blend as a postoperative anti-adhesion agent. J. Biomed. Mater. Res. Part B Appl. Biomater. 2017, 105, 1906–1915. [Google Scholar] [CrossRef]
- Buddhiranon, S.; Define, L.A.; Alexander, T.S.; Kyu, T. Genistein-Modified Poly(ethylene oxide)/Poly(d,l-lactic acid) Electrospun Mats with Improved Antioxidant and Anti-inflammatory Properties. Biomacromolecules 2013, 14, 1423–1433. [Google Scholar] [CrossRef]
- Esmaeili, A.; Haseli, M. Optimization, synthesis, and characterization of coaxial electrospun sodium carboxymethyl cellu-lose-graft-methyl acrylate/poly(ethyleneoxide) nanofibers for potential drug-delivery applications. Carbohydr. Polym. 2017, 17, 645–653. [Google Scholar] [CrossRef]
- Li, Z.; Mei, S.; Dong, Y.; She, F.; Li, Y.; Li, P.; Kong, L. Functional Nanofibrous Biomaterials of Tailored Structures for Drug Delivery—A Critical Review. Pharmaceutics 2020, 12, 522. [Google Scholar] [CrossRef]
- Kamaly, N.; Yameen, B.; Wu, J.; Farokhzad, O.C. Degradable Controlled-Release Polymers and Polymeric Nanoparticles: Mechanisms of Controlling Drug Release. Chem. Rev. 2016, 116, 2602–2663. [Google Scholar] [CrossRef]
- Caballero-George, C.; Marin, E.; Briceño, M.I. Critical evaluation of biodegradable polymers used in nanodrugs. Int. J. Nanomed. 2013, 8, 3071–3090. [Google Scholar] [CrossRef] [PubMed]
- Perinelli, D.R.; Fagioli, L.; Campana, R.; Lam, J.K.; Baffone, W.; Palmieri, G.F.; Casettari, L.; Bonacucina, G. Chitosan-based nanosystems and their exploited antimicrobial activity. Eur. J. Pharm. Sci. 2018, 117, 8–20. [Google Scholar] [CrossRef]
- Yan, T.; Li, C.; Ouyang, Q.; Zhang, D.; Zhong, Q.; Li, P.; Li, S.; Yang, Z.; Wang, T.; Zhao, Q. Synthesis of gentamicin-grafted-chitosan with improved solubility and antibacterial activity. React. Funct. Polym. 2019, 137, 38–45. [Google Scholar] [CrossRef]
- Shemesh, M.; Zilberman, M. Structure-property effects of novel bioresorbable hybrid structures with controlled release of an-algesic drugs for wound healing applications. Acta Biomater. 2014, 10, 1380–1391. [Google Scholar] [CrossRef]

| Bacteria | Inhibition Size of A (mm) | Inhibition Size of B (mm) | Inhibition Size of C (mm) | Inhibition Size of D (mm) |
|---|---|---|---|---|
| E. coli | 12.5 | 12.1 | 3.6 | 14.9 |
| S. aureus | 16.0 | 15.8 | - | 15.4 |
| P. aeruginosa | 10.7 | 10.1 | - | 11.2 |
Publisher’s Note: MDPI stays neutral with regard to jurisdictional claims in published maps and institutional affiliations. |
© 2021 by the authors. Licensee MDPI, Basel, Switzerland. This article is an open access article distributed under the terms and conditions of the Creative Commons Attribution (CC BY) license (https://creativecommons.org/licenses/by/4.0/).
Share and Cite
Li, Z.; Mei, S.; Dong, Y.; She, F.; Li, P.; Li, Y.; Kong, L. Multi-Functional Core-Shell Nanofibers for Wound Healing. Nanomaterials 2021, 11, 1546. https://doi.org/10.3390/nano11061546
Li Z, Mei S, Dong Y, She F, Li P, Li Y, Kong L. Multi-Functional Core-Shell Nanofibers for Wound Healing. Nanomaterials. 2021; 11(6):1546. https://doi.org/10.3390/nano11061546
Chicago/Turabian StyleLi, Zhen, Shunqi Mei, Yajie Dong, Fenghua She, Puwang Li, Yongzhen Li, and Lingxue Kong. 2021. "Multi-Functional Core-Shell Nanofibers for Wound Healing" Nanomaterials 11, no. 6: 1546. https://doi.org/10.3390/nano11061546
APA StyleLi, Z., Mei, S., Dong, Y., She, F., Li, P., Li, Y., & Kong, L. (2021). Multi-Functional Core-Shell Nanofibers for Wound Healing. Nanomaterials, 11(6), 1546. https://doi.org/10.3390/nano11061546

